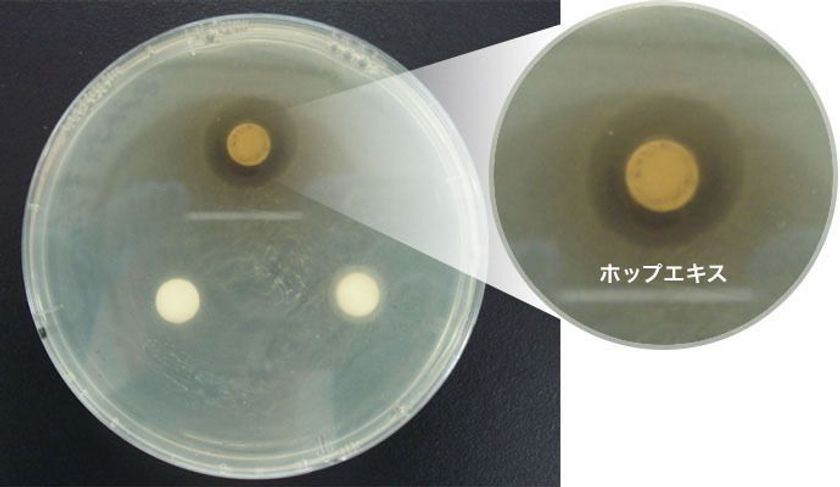
「ホップ」にのど炎症原因菌の殺菌効果！
のど飴のパイオニア企業「カンロ」が確認

カンロ株式会社
- 製造/生産
- 食品
- 食料品






カンロ株式会社
2018年11月28日 14:00


カンロ株式会社 国立音楽大学
2018年11月26日 12:00


カンロ株式会社
2018年11月13日 11:00


カンロ株式会社
2018年11月9日 15:30


カンロ株式会社
2018年11月8日 17:00


カンロ株式会社
2018年11月6日 18:15


カンロ株式会社
2018年10月10日 15:00


カンロ株式会社
2018年10月3日 10:00


カンロ株式会社
2018年10月2日 11:30


カンロ株式会社
2018年9月25日 09:30


カンロ株式会社
2018年9月10日 17:45


カンロ株式会社
2018年9月4日 16:30


カンロ株式会社
2018年8月28日 11:15


カンロ株式会社
2018年8月2日 09:45


カンロ株式会社
2018年8月1日 10:30


カンロ株式会社
2018年7月20日 13:30


カンロ株式会社
2018年7月18日 14:00


カンロ株式会社
2018年7月18日 09:30


カンロ株式会社
2018年7月12日 12:00

カンロ株式会社
2018年7月5日 11:00


カンロ株式会社
2018年7月3日 14:00


カンロ株式会社
2018年6月18日 11:00


カンロ株式会社
2018年5月28日 10:30


カンロ株式会社
2018年5月7日 11:00


カンロ株式会社
2018年4月17日 10:30


カンロ株式会社
2018年3月15日 10:00


カンロ株式会社
2018年3月13日 14:00


カンロ株式会社
2018年3月2日 10:00


カンロ株式会社
2018年3月1日 10:00


カンロ株式会社
2018年1月31日 14:30


カンロ株式会社
2018年1月26日 14:00


カンロ株式会社
2018年1月17日 14:00


カンロ株式会社
2017年12月4日 14:00


カンロ株式会社
2017年12月1日 14:00


カンロ株式会社
2017年11月17日 14:00


カンロ株式会社
2017年11月16日 14:00


カンロ株式会社
2017年11月10日 14:00


カンロ株式会社
2017年11月10日 10:00


カンロ株式会社
2017年10月26日 14:00


カンロ株式会社
2017年10月13日 14:00


カンロ株式会社
2017年10月6日 14:00


カンロ株式会社
2017年10月2日 10:00


カンロ株式会社
2017年9月22日 14:00


カンロ株式会社
2017年9月20日 14:00


カンロ株式会社
2017年9月19日 16:00


カンロ株式会社
2017年9月11日 14:00


カンロ株式会社
2017年9月7日 14:00


カンロ株式会社
2017年9月6日 14:00


カンロ株式会社
2017年9月5日 14:00


カンロ株式会社
2017年8月28日 14:00


カンロ株式会社
2017年8月25日 14:00


カンロ株式会社
2017年8月24日 14:00


カンロ株式会社
2017年8月18日 14:00


カンロ株式会社
2017年8月7日 15:00


カンロ株式会社
2017年7月28日 14:00


カンロ株式会社
2017年7月24日 14:00


カンロ株式会社
2017年7月21日 14:00


カンロ株式会社
2017年7月19日 09:30


カンロ株式会社
2017年7月5日 14:00


カンロ株式会社
2017年7月3日 11:00


カンロ株式会社
2017年6月29日 11:00


カンロ株式会社
2017年6月9日 11:00


カンロ株式会社
2017年6月7日 14:00


カンロ株式会社
2017年6月5日 14:00


カンロ株式会社
2017年6月2日 14:00


カンロ株式会社
2017年5月19日 15:00


カンロ株式会社
2017年5月15日 14:00


カンロ株式会社
2017年5月12日 14:00


カンロ株式会社
2017年5月1日 15:00


カンロ株式会社
2017年4月28日 11:00


カンロ株式会社
2017年4月27日 11:00


カンロ株式会社
2017年4月7日 11:00


カンロ株式会社
2017年3月23日 15:00


カンロ株式会社
2017年3月15日 11:00


三和交通株式会社、カンロ株式会社
2017年3月13日 10:30


カンロ株式会社
2016年11月24日 10:30


カンロ株式会社
2016年10月17日 11:00


カンロ株式会社
2016年6月14日 14:30


カンロ株式会社
2016年2月16日 15:00


カンロ株式会社
2016年2月15日 12:00


カンロ株式会社
2016年2月5日 11:00


カンロ株式会社
2016年2月1日 14:00


カンロ株式会社
2015年12月21日 11:00


カンロ株式会社
2015年12月15日 14:00


カンロ株式会社
2015年11月20日 15:00


カンロ株式会社
2015年11月17日 17:30


カンロ株式会社
2015年11月16日 14:00


カンロ株式会社
2015年11月13日 16:00


カンロ株式会社
2015年11月4日 11:30


カンロ株式会社
2015年10月29日 13:00


カンロ株式会社
2015年10月5日 13:30


カンロ株式会社
2015年9月17日 14:00


カンロ株式会社
2015年9月17日 12:00


カンロ株式会社
2015年9月10日 10:30


カンロ株式会社
2015年3月17日 12:00


カンロ株式会社
2015年3月6日 12:00


カンロ株式会社
2015年2月4日 12:00


カンロ株式会社
2014年11月4日 10:30


カンロ株式会社
2014年10月27日 14:00


カンロ株式会社
2014年9月16日 10:00